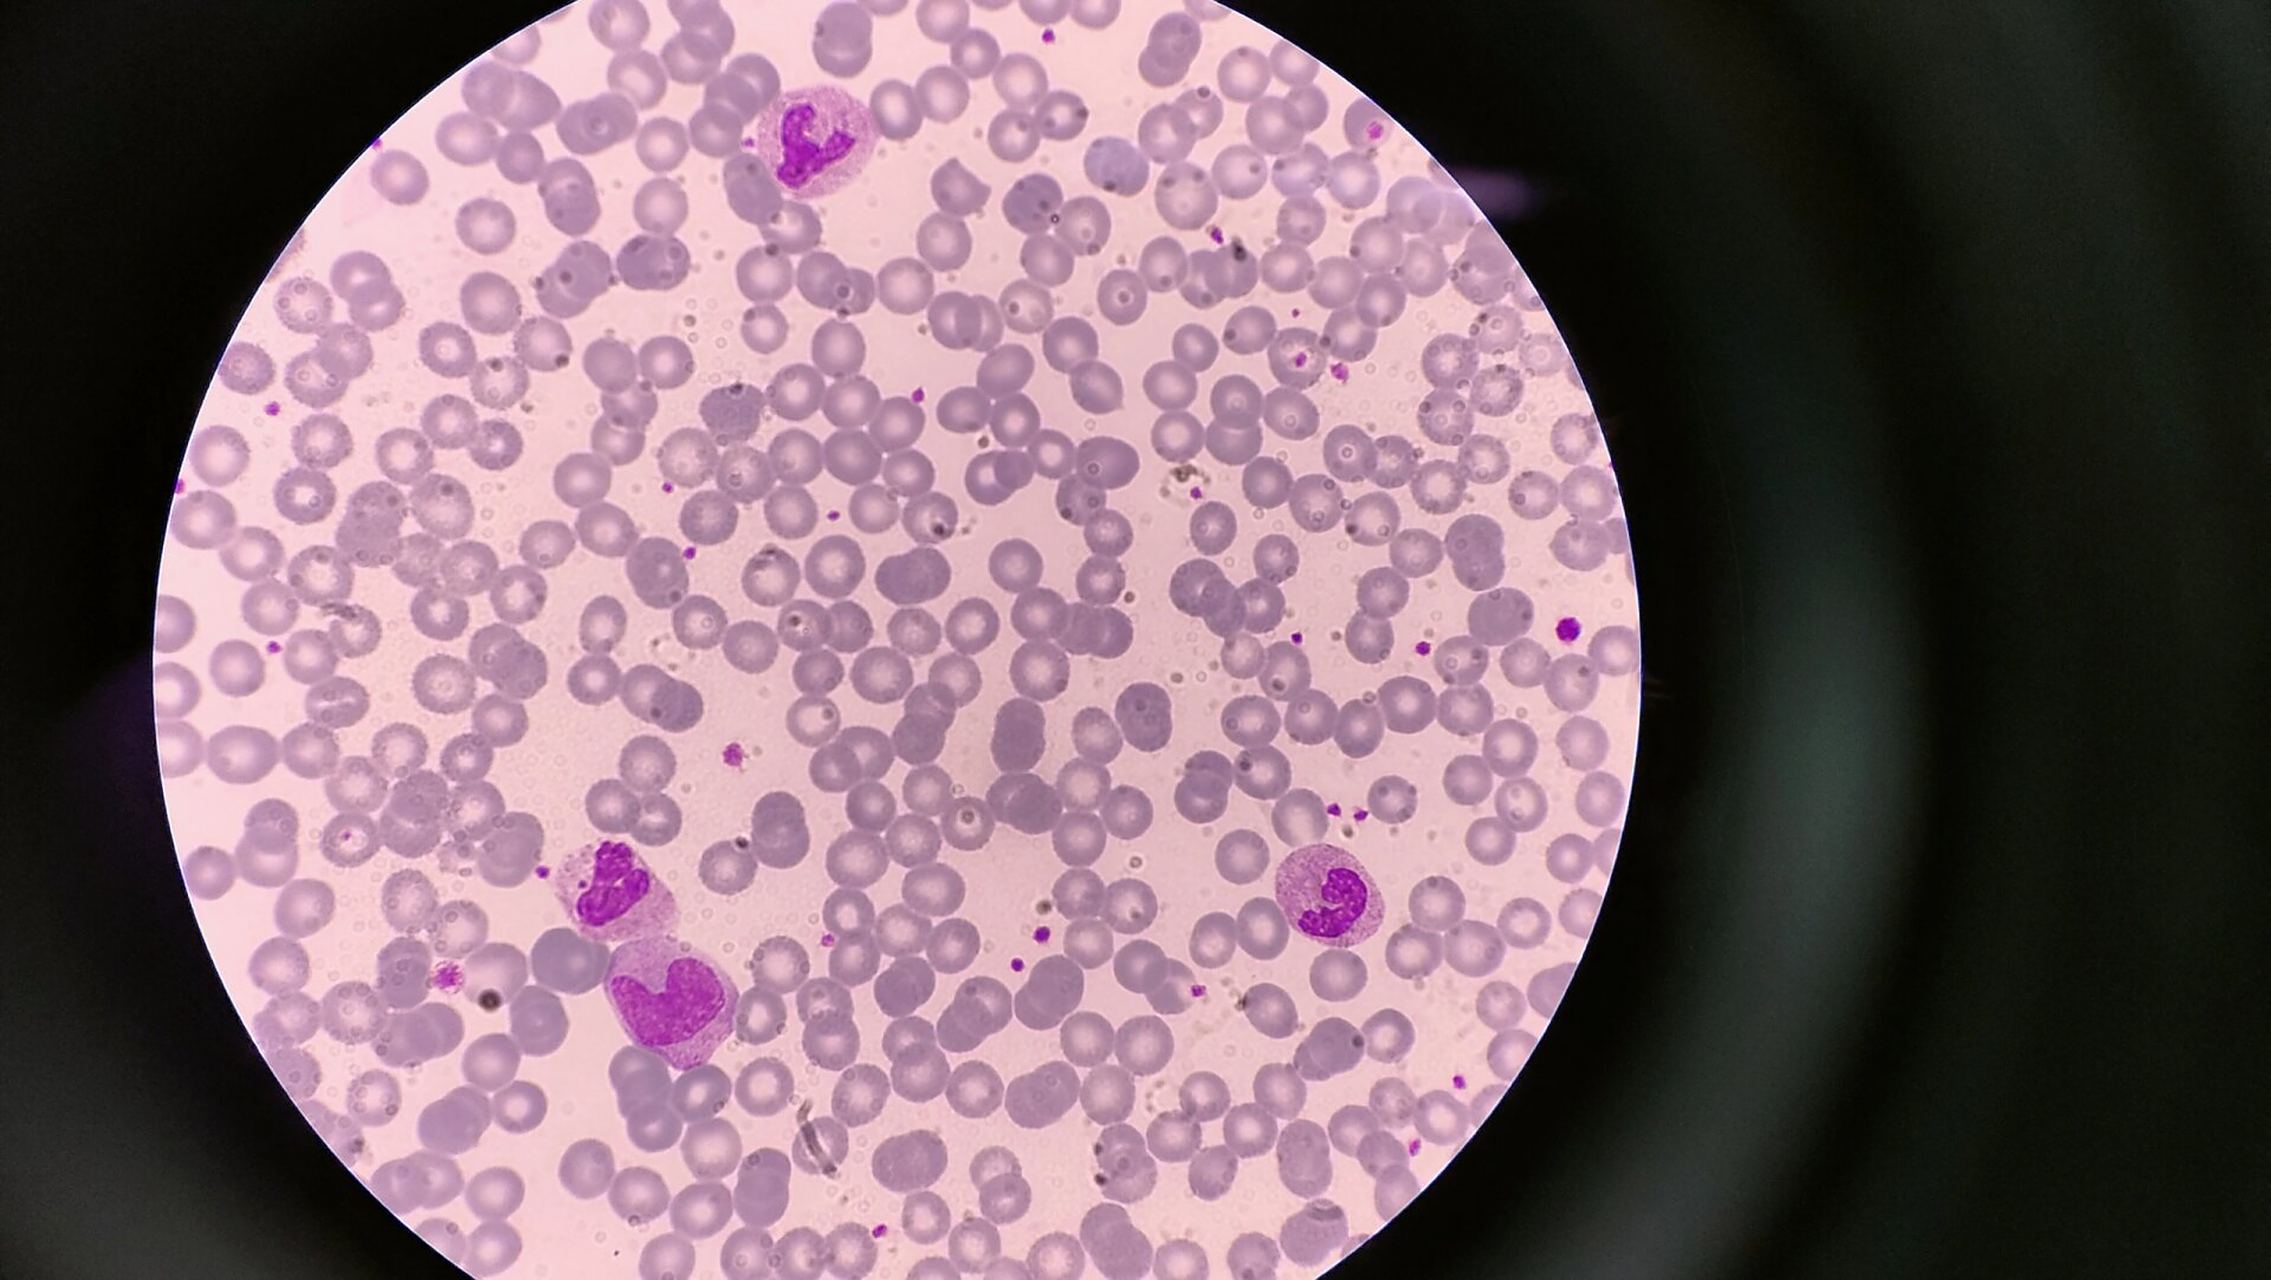
分享今日血标本 还是得多练练推血涂片
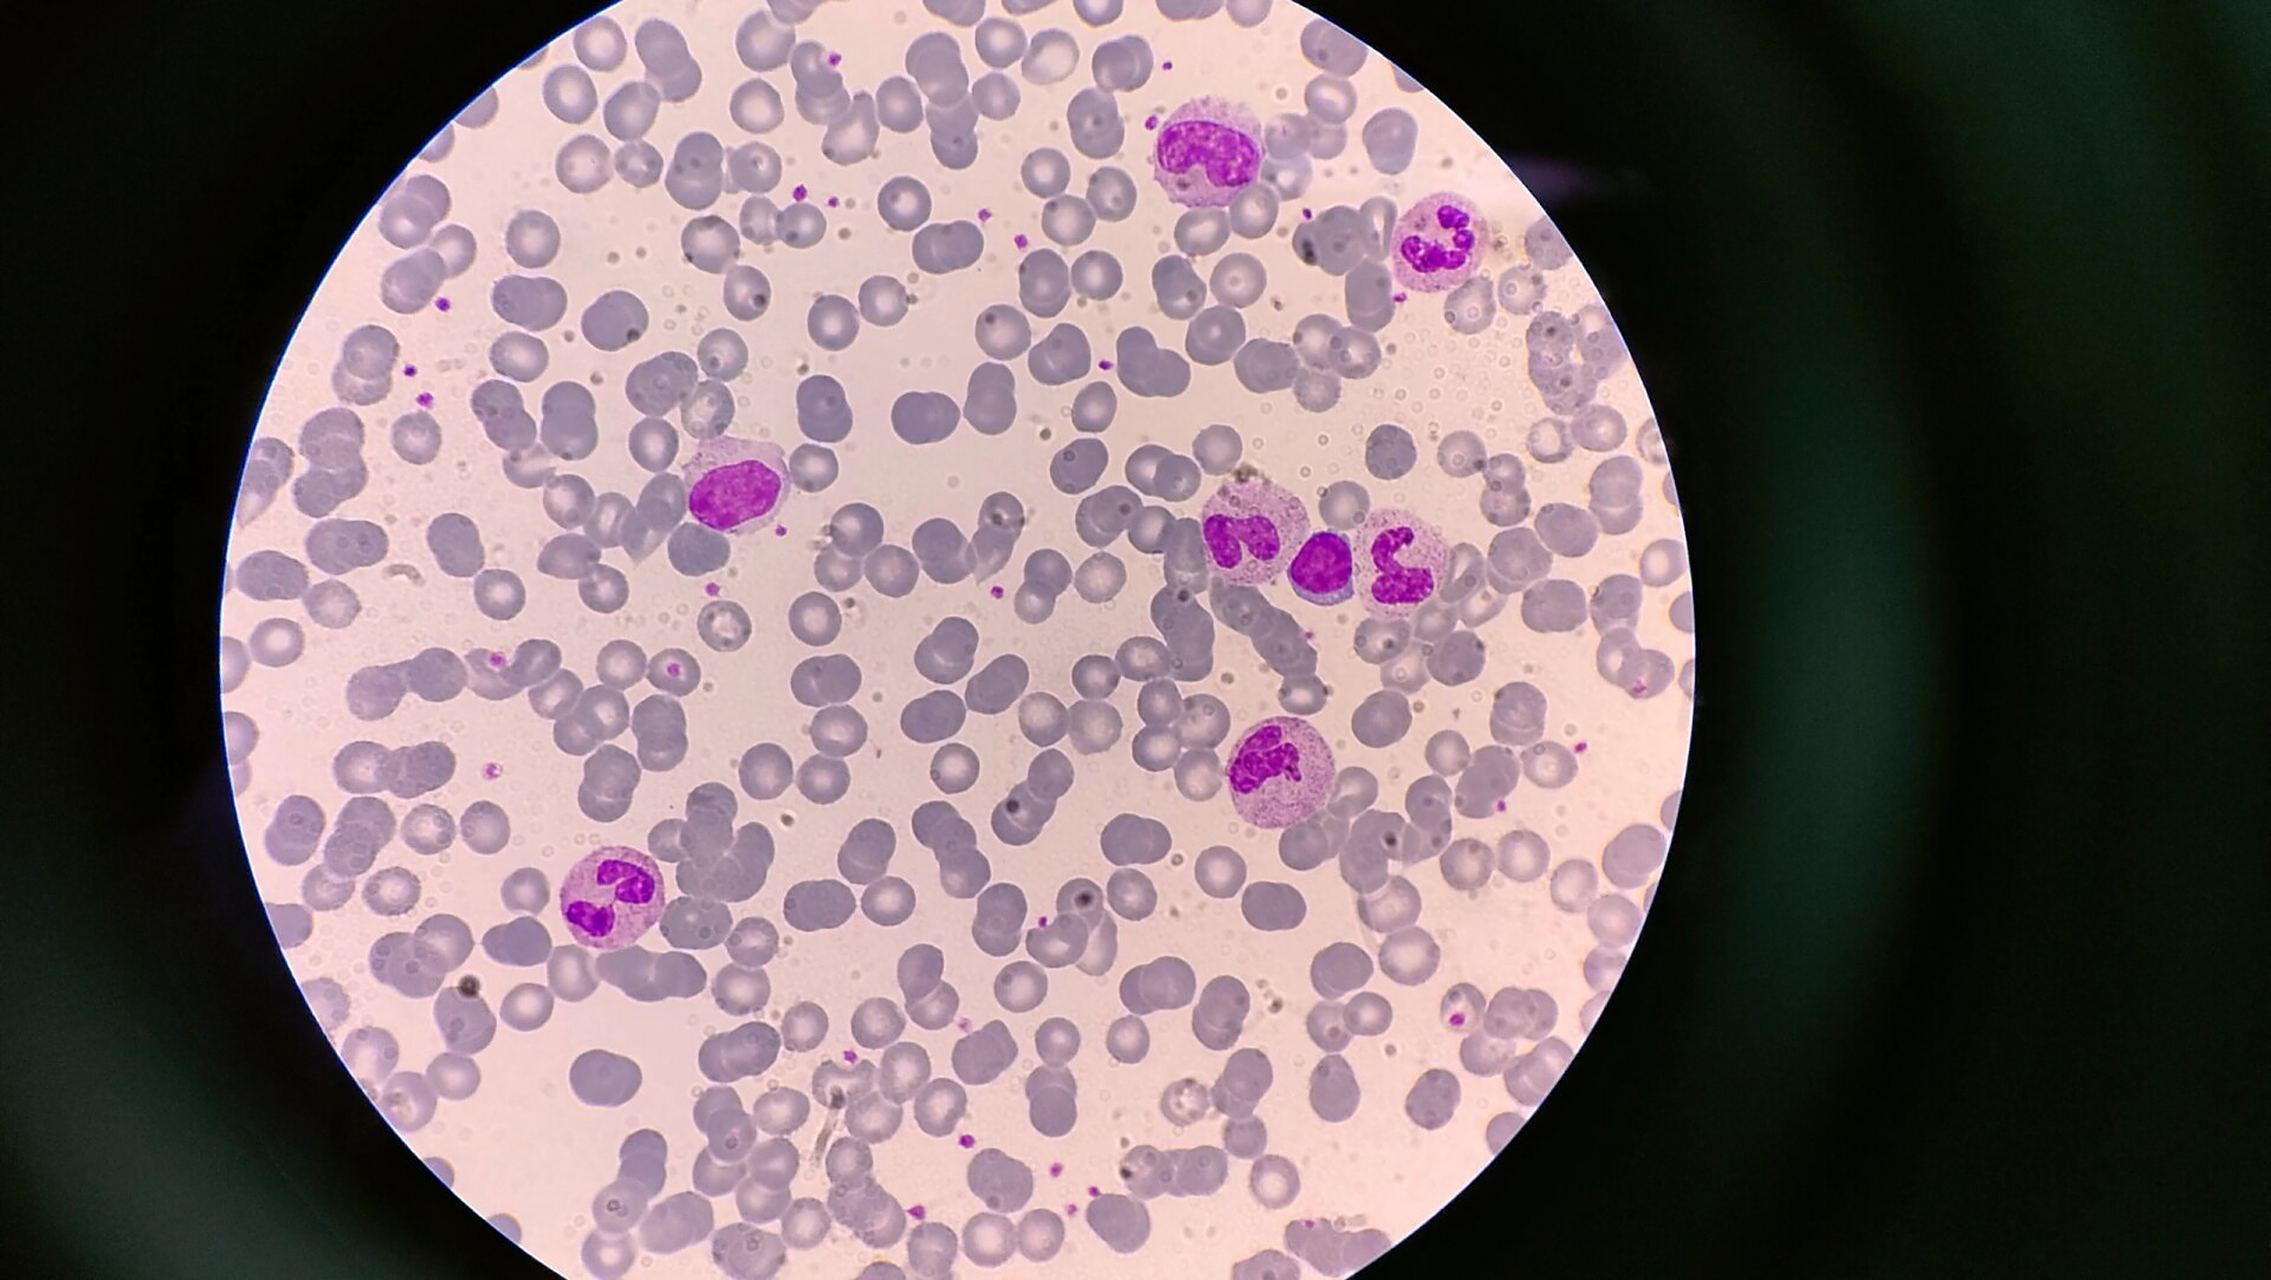
分享今日血标本 还是得多练练推血涂片

推血涂片图片

得这张血涂片可以打多少分 哈哈 一气呵成 每次推血涂片讲究的是手感
图片尺寸1337x1280
分享今日血标本 还是得多练练推血涂片
图片尺寸2271x1280
只要推片时做到速度慢而匀速,角度小,最后就能得到合格漂亮的血涂片啦
图片尺寸640x348
分享今日血标本 还是得多练练推血涂片
图片尺寸2271x1280
农牧与生物工程系技术技能节——静脉采血与血涂片制备
图片尺寸1080x1440
如何制作一张满意的血涂片
图片尺寸600x506
推个血片都是爱你的形状,我的情话止步于此了血细胞形态真的差不多忘
图片尺寸1080x1080
职业病防治院工会举办血涂片推片技能竞赛
图片尺寸1080x1080
今天被老前辈夸的血涂片
图片尺寸1440x1920
异常白细胞或者血小板低就需要推血涂片,一次推不成就继续推舌头状是
图片尺寸1080x1439
血涂片染色
图片尺寸1200x781
外周血涂片amlm5
图片尺寸1152x720
职业病防治院工会举办血涂片推片技能竞赛
图片尺寸1080x1080
血涂片制备 老师要求末梢采血完,直接蘸取推片,甩干,这不多练,真的推
图片尺寸1536x2048
求教关于推血涂片的技巧
图片尺寸3840x5120
实验五血涂片的制备和染色血细胞形态观察与血型鉴定ppt课件
图片尺寸920x690
血涂片的制作与染色技术
图片尺寸640x472
血涂片显示急性髓细胞白血病(aml).照片
图片尺寸302x300
血涂片
图片尺寸601x612
推玻片 血涂片 骨髓推片 显微镜 7101载玻片 厚度1.
图片尺寸800x800